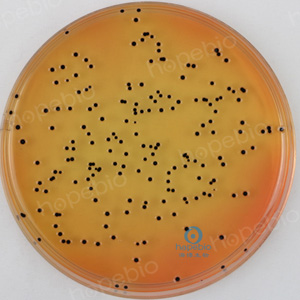

海博微信公众号
海博微信公众号
 海博天猫旗舰店
海博天猫旗舰店


 海博微信公众号
海博微信公众号
 海博天猫旗舰店
海博天猫旗舰店




食品安全是人类健康的基石,而食源性致病菌则是这块基石上最常出现的裂痕。这些肉眼无法察觉的微生物,潜藏在我们的日常饮食中,随时可能引发从轻微不适到致命危疾的各类疾病。据世界卫生组织估计,每年全球有数亿人因食用受污染的食物而患病,其中数十万人不幸死亡。因此,深入了解食品中的致病菌,掌握其特性与传播规律,是构建现代食品安全体系、保障公众健康的首要任务。
食品,特别是蛋白质、水分含量高的食品,为微生物的生长繁殖提供了近乎完美的条件:充足的营养、适宜的水分活度、中性的pH值以及丰富的维生素。从农田到餐桌的漫长产业链中,任何一个环节的疏忽—,无论是原料污染、加工设备卫生不合格、交叉感染,还是储存温度不当、人员操作不卫生等都可能为致病菌的侵入和增殖打开方便之门。
一、主要食源性致病菌及其危害
食品中的致病微生物主要包括细菌、病毒、真菌和寄生虫等,其中细菌是导致食物中毒事件中最为常见、种类最多的元凶。
1、沙门氏菌——范围最广的“宿敌”
沙门氏菌是肠杆菌科沙门氏菌属的革兰氏阴性杆菌,无芽孢、有鞭毛,兼性厌氧,广泛存在于受污染的肉类(如猪肉、鸡肉)、蛋类、乳制品及未煮熟的豆制品中。该菌通过污染食品进入人体后,主要侵袭肠道黏膜,释放内毒素,引发急性胃肠炎,症状包括高热、呕吐、腹痛、水样腹泻等。对于婴幼儿、老年人、免疫力低下人群(如艾滋病患者、癌症患者),感染可发展为败血症、脑膜炎等全身性疾病,致死率可达10%-30%,是全球食源性疾病的主要致病菌之一。
沙门氏菌检测用到的分离培养基主要有SS琼脂、胆硫乳琼脂(DHL)、HE琼脂、木糖赖氨酸脱氧胆盐(XLD)琼脂、亚硫酸铋(BS)琼脂等。
图1 沙门氏菌在SS琼脂培养基上的菌落形态
2、金黄色葡萄球菌——毒素型中毒的“元凶”
金黄色葡萄球菌是葡萄球菌属的革兰氏阳性球菌,呈葡萄串状排列,无芽孢、无鞭毛,兼性厌氧。该菌广泛存在于人体皮肤、鼻腔黏膜及受污染的食品中,尤其在高糖、高脂肪的食品(如奶油蛋糕、熏肉、乳制品)中易繁殖。其致病性主要源于产生的肠毒素,该毒素耐热性强,即使食品经过加热处理,毒素仍可能残留。人摄入含肠毒素的食品后,通常在2-6小时内出现中毒症状,表现为恶心、剧烈呕吐、腹痛、腹泻等,严重时可导致脱水和电解质紊乱。此外,金黄色葡萄球菌还可能引发皮肤感染、败血症等全身性疾病,对食品加工行业的安全生产构成严重威胁。
常用的检测金黄色葡萄球菌的培养基主要有Baird-Parker琼脂培养基和甘露醇高盐琼脂培养基等。


图2 金黄色葡萄球菌在Baird-Parker琼脂和甘露醇高盐琼脂培养基上的菌落形态
3、单核细胞增生李斯特菌——冷藏柜里的“潜伏杀手”
李斯特菌是李斯特菌属的革兰氏阳性短杆菌,无芽孢、有鞭毛(20℃-25℃时运动活跃),兼性厌氧,具有极强的环境适应性,耐低温(可在0℃-4℃冷藏环境中生长,故被称为“冰箱杀手”)、耐高盐(可耐受20%氯化钠)、耐酸性(pH4.5-9.0均可存活)。其污染食品以冷藏即食食品为主,如熟肉制品(火腿、香肠)、奶酪、冰淇淋、即食蔬菜沙拉等。
李斯特菌感染引发的李斯特菌病,潜伏期可长达数周,感染后初期症状类似流感(发热、头痛、肌肉酸痛),但对孕妇、胎儿、老年人及免疫力低下者危害极大,孕妇感染可导致流产、死胎或新生儿败血症;老年人感染易发展为脑膜炎、败血症,致死率高达20%-30%,是致死性最强的食源性微生物之一。
常用的检测李斯特菌的培养基主要有牛津琼脂培养基和李氏增菌培养基等。

图3 李斯特菌在牛津琼脂培养基上的菌落形态
4、副溶血性弧菌——海产品的“专属威胁”
副溶血性弧菌是弧菌科弧菌属的革兰氏阴性弧状细菌,无芽孢、有单鞭毛(运动活泼),兼性厌氧,具有典型的“嗜盐性”,生长需氯化钠浓度为2%-4%(无盐环境中不能生长),主要污染海产品(如虾、蟹、贝类、带鱼)及腌制食品(如咸菜、咸鱼),尤其在夏季高温季节,海产品易因储存不当滋生该菌。
副溶血性弧菌感染引发的食源性疾病,潜伏期为2-24小时,主要症状为急性胃肠炎(腹痛、腹泻、呕吐、发热),腹泻多为水样便或黏液便,严重者可出现脱水、休克,对于老年人、儿童及有基础疾病者,致死率约为1%-3%,是沿海地区夏季食源性疾病的主要致病菌。
常用的检测副溶血性弧菌的培养基主要有TCBS琼脂培养基等。

图4 副溶血性弧菌在TCBS琼脂培养基上的菌落形态
5、致泻大肠埃希氏菌——粪便污染的“指示针”
致泻大肠埃希氏菌是近年来我国细菌性食源性疾病暴发事件中的“常客”,其适应能力强,在多种食品中都能存活。高危食品主要包括肉制品(如未彻底煮熟的香肠、肉饼)、新鲜蔬菜(如生食的生菜、黄瓜)和水果(如草莓、哈密瓜)等。任何人都有可能感染该菌,但老人和儿童由于免疫力较弱,更容易成为受害者,且症状往往更为严重。感染后,患者常出现水样便、腹部剧烈疼痛、恶心呕吐、发热等症状,部分患者粪便中还会带有少量粘液和血丝,婴幼儿感染后甚至可能出现持续2周以上的慢性腹泻,严重影响生长发育。
6、肉毒梭菌
肉毒梭菌是梭菌属的革兰氏阳性厌氧菌,能产生剧毒的肉毒毒素,是目前已知毒性最强的细菌毒素之一,致死机制是毒素抑制神经递质乙酰胆碱释放,导致肌肉松弛性麻痹,引发呼吸衰竭死亡。该菌为产芽孢细菌,芽孢耐热性极强(可耐受100℃煮沸数小时,121℃高压灭菌需30分钟以上才能杀灭),广泛存在于土壤、淤泥、动物粪便中,主要污染密封发酵食品(如自制豆瓣酱、腐乳)、罐头食品(尤其是低酸性罐头,如肉类罐头、鱼类罐头)、腌制肉类(如腊肉、咸鱼)。
肉毒梭菌感染引发的肉毒中毒,潜伏期通常为12-36小时,初期症状为头晕、乏力、视力模糊、吞咽困难,随后出现全身肌肉麻痹,最终因呼吸肌麻痹导致窒息死亡,若未及时使用抗毒素治疗,致死率高达50%-80%。
二、食品中易被忽视的各类致病菌
1、克罗诺杆菌属(阪崎肠杆菌)
克罗诺杆菌属(阪崎肠杆菌)是一种极具“韧性”的致病菌,它具备耐热、耐干燥、对渗透压忍耐力强的特点,即便在干燥的环境中也能长时间存活,这使得它在食品加工和储存过程中难以被彻底清除。不过,该菌并非对所有人都有高风险,其主要威胁对象是6月龄以下的婴儿。婴儿感染后,可能引发新生儿脑膜炎、菌血症等严重疾病,病死率较高。常见的污染食品集中在婴儿配方食品、特殊医学用途婴儿配方食品中,一旦冲调过程卫生不达标或配方食品本身在生产环节被污染,就可能给脆弱的婴儿群体带来致命风险。
2、志贺氏菌(痢疾杆菌)
志贺氏菌,又称痢疾杆菌,是引发细菌性痢疾的“罪魁祸首”,在卫生条件较差的地区尤为常见。它主要通过被污染的食物和饮用水传播,比如食用了被患者或带菌者粪便污染的蔬菜、水果、凉拌菜,或饮用了未经消毒的生水等。志贺氏菌进入人体后,会在肠道内大量繁殖,破坏肠道黏膜,引发肠道炎症。患者通常会出现高热、腹痛、频繁腹泻、里急后重(有排便感但排便困难)等症状,粪便多为脓血便,严重时会因剧烈腹泻导致脱水和电解质紊乱,若治疗不及时,还可能引发中毒性休克等并发症。
3、产气荚膜梭菌
产气荚膜梭菌是一种典型的厌氧性细菌,在无氧或缺氧环境下能快速生长繁殖,并产生多种毒性极强的毒素和酶。它广泛存在于土壤、人和动物的肠道中,因此容易污染肉类(如牛肉、猪肉)、蛋类等食品,尤其是在食品储存温度不当(如长时间处于20℃-40℃的危险温度区)时,该菌会迅速滋生。感染产气荚膜梭菌后,人体可能面临两种主要疾病,一是气性坏疽,多发生在伤口感染后,细菌在伤口内繁殖并产生气体,导致组织坏死;二是食物中毒,患者会出现剧烈腹痛、腹泻、呕吐等症状,虽然病程较短,但会给身体带来极大不适。
4、蜡样芽孢杆菌
蜡样芽孢杆菌是一种分布广泛的革兰氏阳性杆菌,在土壤、空气、灰尘、植物表面等环境中几乎无处不在。它最大的特点是能产生具有极强抵抗力的芽孢,这些芽孢能耐受高温、干燥、消毒剂等不良环境,即便经过普通烹饪加热,也可能存活下来,在食品冷却和储存过程中重新萌发成具有致病性的细菌。蜡样芽孢杆菌常污染大米(尤其是隔夜米饭)、大豆制品(如豆腐、豆浆)、谷物(如玉米、小麦制品)等食品,在适宜的温度下会产生呕吐毒素和腹泻毒素。人食用被污染的食品后,通常在几小时内出现恶心、呕吐、腹痛、腹泻等食物中毒症状,严重程度因摄入毒素量而异。
5、空肠弯曲菌
空肠弯曲菌是一种微需氧菌,对氧气浓度有特定要求,主要存在于家禽(如鸡、鸭)、家畜(如猪、牛)的肠道内。它的传播途径主要有两种:一是直接接触受感染的动物,二是食用被污染的食品,如未彻底煮熟的鸡肉、猪肉,被污染的生牛奶、鸡蛋等。空肠弯曲菌是导致人类急性肠炎的常见病因之一,感染后患者会出现发热、腹部痉挛性疼痛、腹泻等症状,部分患者的粪便中会带有血液,病程通常持续1-10天,免疫力低下者可能会出现病情迁延的情况。
三、相关产品
部分可检测致病菌的培养基:
|
产品货号 |
产品名称 |
用途 |
|
HB4089 |
用于沙门氏菌,志贺氏菌的选择性分离培养(GB标准) |
|
|
HB4087 |
肠道菌选择性培养基,特别是沙门氏菌的选择性分离(GB、SN标准) |
|
|
HB4093-5 |
用于沙门氏菌选择性分离培养 |
|
|
HB4105-12 |
用于沙门氏菌的选择性分离培养 |
|
|
HB4090-6 |
用于沙门氏菌选择性分离培养 |
|
|
HB4128 |
用于金黄色葡萄球菌的选择性分离培养。 |
|
|
HB4130 |
用于致病性弧菌的选择性分离。 |
注:本文属海博生物原创,未经允许不得转载。
上一篇:孟加拉红在细菌培养中的作用
| 相关文章: | ||



